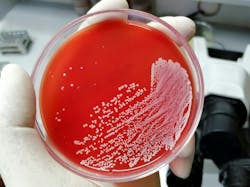
66bb718e6151bb5f5da8e322 Adobestock 482355351 66bb718e6151bb5f5da8e322 Adobestock 482355351

BD posted an update regarding the blood culture vial shortage on July 26.
According to BD’s statement, “Based on actions currently deployed at our supplier and the temporary sourcing of glass bottles for BD BACTEC Lytic/10 Anaerobic/F Culture Vials, we expect to realize improvements in the September 2024 supply. In the interim, BD will continue to fill customer orders regularly and as supply is available. As this is a dynamic and evolving situation, we will provide another supply update by September 2024.
Recommended Actions:
- Assess current inventory levels of BD BACTEC blood culture media in your system warehouse, laboratory, unit, and nursing stations.
- Prioritize the use of blood culture media based on clinical need and following guidelines of local oversight committees, such as the most recent update from IDSA and/or the World Health Organization as applicable to your region.
- Partner with your internal clinical teams to align on and implement a BD BACTEC™ blood culture media utilization strategy.
- Emphasize the importance of proper blood volume collection and disinfection of skin protocols with collectors to optimize recovery and minimize false positive results, respectively. (Revisit local guidelines such as CLSI)”
BD also announced a collaboration with the Food and Drug Administration to explore resolutions. BD listed some actions they’ve taken already in a release:
- “Working directly with our raw material supplier of molded bottles to improve production line efficiency and output
- Early placement of BD BACTEC media on manual allocation to closely manage supply and ensure equitable distribution
- Reducing transit times where possible with air shipment to meet regional needs and improve inventory levels
- Modifying manufacturing schedules to rapidly respond to bottle shipments from our supplier”
About the Author
Sign up for our eNewsletters
Get the latest news and updates